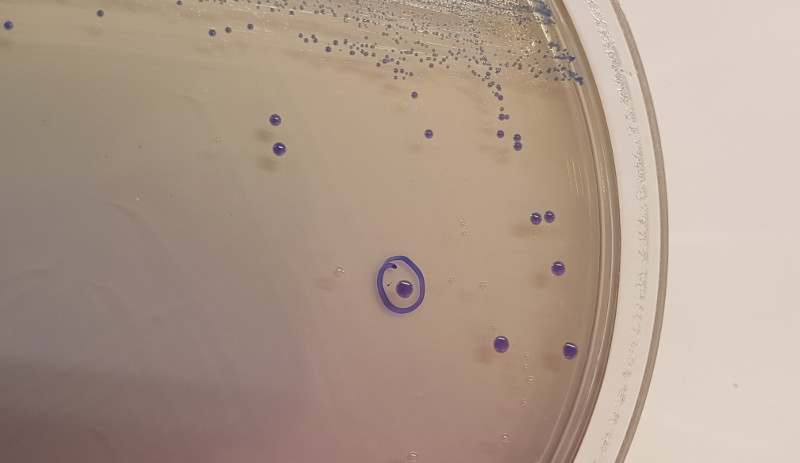
Aislamiento de bacterias probióticas (Lactobacillus) procedentes de aves salvajes en el laboratorio del hospital de fauna de GREFA.

Aislamiento de bacterias probióticas (Lactobacillus) procedentes de aves salvajes en el laboratorio del hospital de fauna de GREFA.Nuestra especialización en fauna salvaje permite la participación creciente de GREFA en proyectos muy interesantes aunque poco conocidos. Uno de ellos es Bioprotect, en el que llevamos colaborando ya un año. Es buen momento para contaros en qué consiste este proyecto, donde nuestra principal contribución está siendo la búsqueda de bacterias procedentes de las aves silvestres que puedan servir como alternativa al uso de antibióticos en el sector avícola.
Aislamiento de bacterias probióticas (Lactobacillus) procedentes de aves salvajes en el laboratorio del hospital de fauna de GREFA.Nuestra especialización en fauna salvaje permite la participación creciente de GREFA en proyectos muy interesantes aunque poco conocidos. Uno de ellos es Bioprotect, en el que llevamos colaborando ya un año. Es buen momento para contaros en qué consiste este proyecto, donde nuestra principal contribución está siendo la búsqueda de bacterias procedentes de las aves silvestres que puedan servir como alternativa al uso de antibióticos en el sector avícola.
Hace un año que arrancó Bioprotect. Aprobado en 2018, este proyecto con una duración de tres años y medio cuenta con la participación de dos empresas del sector avícola (Coob Española y Huevos León), el Instituto de Agroquímica y Tecnología de Alimentos (IATA), del CSIC, y el Hospital de Fauna Salvaje de GREFA. El objetivo principal es encontrar un sustituto natural, ecológico, económico y eficaz a los antibióticos utilizados en granjas avícolas para reducir la incidencia de colibacilosis, de manera que se reduzca o minimice en la medida de lo posible la aparición de nuevas resistencias.
Para ello tenemos dos grandes líneas de trabajo: por un lado, el aislamiento de las bacterias que causan dicha enfermedad en las granjas y, por otro lado, la obtención de bacterias con poder probiótico procedentes de las aves silvestres. En este caso buscamos bacterias que sean capaces de inhibir el crecimiento de Escherichia coli. Al aislar las bacterias probióticas de aves silvestres minimizamos el contacto previo de esos microorganismos con los antibióticos y, por lo tanto, la probabilidad de que hayan desarrollado resistencias a antibióticos es mínima.
 Aislamiento en laboratorio de Escherichia coli, causante de colibacilosis.
Aislamiento en laboratorio de Escherichia coli, causante de colibacilosis.
Bioprotect tiene la particularidad de que es un proyecto RETOS. ¿Qué significa esto? Hablamos de proyectos I+D que son seleccionados en base al posible avance científico que puedan llegar a suponer y que reciben financiación europea. De esta manera pretenden promover la investigación orientada a la búsqueda de soluciones a algunos de los grandes problemas presentes en la sociedad, incluyendo los relacionados con la calidad alimentaria, la actividad agraria productiva y sostenible y la sostenibilidad de los recursos naturales. Las ayudas económicas que reciben son destinadas a personal, equipamiento, materiales y otros gastos relacionados con el desarrollo del proyecto.
 |
Este proyecto está financiado por el Fondo Europeo de Desarrollo Regional (FEDER) de la Unión Europea y el Ministerio de Ciencia, Innovación y Universidades – Agencia Estatal de Investigación con el objetivo de promover el desarrollo tecnológico, la innovación y una investigación de calidad. Proyecto: RTC-2017-6235-2.
Recurso genético español, obtenido bajo la Autorización de Acceso a Recursos Genéticos Españoles procedentes de diversos géneros de bacterias lácticas pertenecientes a taxones silvestres para una utilización fines de investigación no comercial. Referencia ESNC114.
 Recogida de muestras de una cigüeña blanca al ingresar en el hospital de fauna de GREFA.
Recogida de muestras de una cigüeña blanca al ingresar en el hospital de fauna de GREFA.












